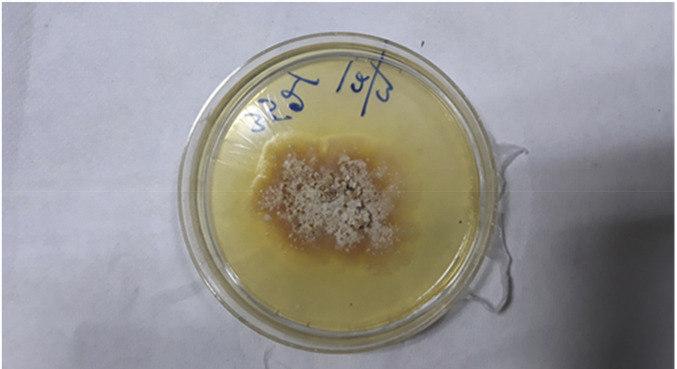
Folha de prata &eacute; uma infec&ccedil;&atilde;o f&uacute;ngica conhecida por afetar a sa&uacute;de de vegetais

Pela primeira vez na história, um humano foi infectado pelo fungo vegetal Chondrostereum purpureum – conhecido por causar a doença das folhas prateadas em plantas, que costuma causar a morte delas. Trata-se de um homem indiano de 61 anos.
O caso foi registrado nos periódico científico Medical Mycology Case Reports.
De acordo com o relato, o paciente era um profissional especializado em micologia de plantas, passando o tempo estudando cogumelos, fungos vegetais e materiais em decomposição como objeto de pesquisa.
Ele chegou ao hospital apresentando rouquidão, tosse, faringite recorrente, fadiga, dificuldade para engolir e anorexia nos três meses anteriores ao atendimento.
Em seu histórico de saúde, não foram registrados problemas como diabetes, infecção por HIV, doença renal ou qualquer doença crônica, assim como não fazia o uso de medicamentos imunossupressores.
O paciente foi submetido a uma tomografia computadorizada, na qual os médicos localizaram uma infecção na traqueia direita, passando, então por uma aspiração do pus encontrado no local.
O material foi encaminhado para análise laboratorial, que apresentou um crescimento de colônia fúngica.
Os médicos, por não conseguirem identificar o fungo de modo visual, enviaram a amostra para o Centro Colaborador da OMS (Organização Mundial da Saúde) para Referência e Pesquisa sobre Fungos de Importância Médica do país.
A partir daí, os especialistas fizeram o sequenciamento de DNA das moléculas e puderam detectar que tratava-se do fungo.
Embora não tenha trabalhado com tal patógeno, os médicos acreditam que a infecção possa ter ocorrido pelo tempo em que ele ficou exposto a materiais em decomposição.
O paciente foi submetido a tratamento durante 60 dias e acompanhado por médicos durante dois anos, estando livre de infecções ou recidivas.
A descoberta dessa primeira infecção chama atenção de médicos, biólogos e cientistas.
"O fato de doenças animais e humanas poderem ser causadas por patógenos de plantas é um novo conceito que levanta sérias questões sobre a propensão de tal infecção ocorrer tanto em indivíduos saudáveis quanto em indivíduos imunocomprometidos", alegam os autores do caso relatado, Ujjwayini Ray e Soma Dutta, do Hospital de Multiespecialidades Apollo, em Kolkata, na Índia.